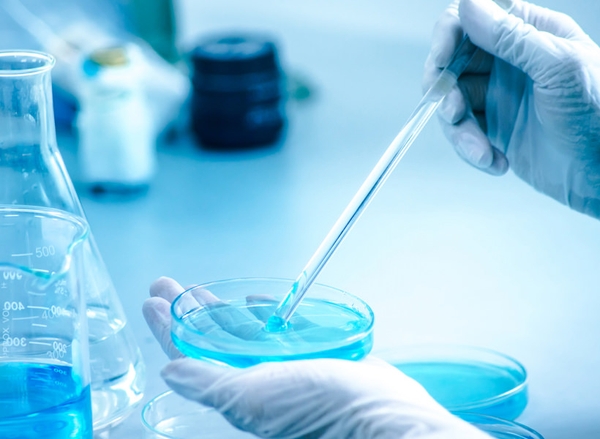

薬でもない!カツラでもない!植毛でもない!正真正銘の地毛の実感が期待できます!
『Step’sプログラム』ではヒト幹細胞培養液を使用し頭皮毛髪にアプローチいたします!
■現在医薬品を内服している方にもおすすめ!

内服薬を飲んでいるけど、効果を実感できない、副作用で内服薬を続けるのが億劫になっている、内服薬を止めるタイミングがわからない、また抜けてしまうのだろうか、など、内服薬には副作用の心配や辞めるタイミングに悩む方も多くいらっしゃいます。薬を飲んでも効果を感じられない方や副作用により体毛も濃くなってしまい脱毛サロンやクリニックを同時に利用し、出費が重なってしまったりなど、思わぬ弊害に悩まれている場合など、薬の内服ではなく頭皮毛髪もいい状態に持ってける方法があれば何よりですよね。
『Step’sプログラム』では頭皮毛髪のケアだけでなく、専門のアドバイザーと生活習慣などトータルなケアアプローチで頭皮毛髪のお悩みに取り組んでおります。
■フケや皮脂など頭皮環境からくる脱毛にも万能!

男性ホルモンの影響からくる髪のボリューム低下や、フケなどの頭皮のターンオーバーの乱れからくる髪の毛のボリュームダウン、ストレス性の強い円形のお悩みなど、髪の毛が少なくなってくるの種類はご自身では判断が難しいほどに種類があります。油分が過剰だったり、逆に乾燥しすぎて白くポロポロとフケが落ちてきたりなども。『Step’sプログラム』ではヒト幹細胞培養液を使用した髪の毛への対策を行いますので、頭皮環境や毛髪の改善に大いにお役立ちいたします。
ターンオーバーの乱れからくるボリューム低下にも幹細胞培養液で効果的に毛のボリュームケアが行えます。植毛やカツラでのケアでは根本的な解決に至らないため、ずっと植毛をし続けていくとなると費用面も含めると継続が難しいとの不安もあります。エステサロンで始める養毛ケアでしっかりとした効果と、お財布にも優しいスカルプケアを。
■幹細胞培養液の濃度に自信!
他社での幹細胞培養液をお試しの方も『Step’sプログラム』の濃度にご注目ください。
濃度50%の高配合製品をご使用いたします。
他社市販製品は5%以下、クリニックで用いれられている幹細胞でも11%程度と、濃度が低く、なのに、施術料金は高く。なのが現状です。本当に効果を実感して欲しいからこそ『Step’sプログラム』は妥協をしない濃度、50%配合を実現いたしました。今まで効果に不満があった方も、高濃度製品を使用することで今までにない自分の毛髪へアプローチが可能です。高濃度培養液はただ塗るだけじゃなく、美容ダーマペンを使用し浸透力を高めたり、頭皮マッサージや赤色低出力レーザーを使用して栄養素を届けることも同時に行います。専門店ならではの美容機器を駆使して頭皮改善をプログラム化を行いました。
■早くくればよかった!知らなくて損した養毛ケア

今まで散々とお金と時間をかけて副作用にも悩まされていた方、ヒト臍帯血幹細胞培養液を使用して、幹細胞培養液って何?という気持ちの方。注射や薬などの本格的なケアで高額な対策が終わりなく続き金銭的な限界が近づいてきていませんか?養毛スカルプサロンで行う『Step’sプログラム』では頭皮への負担もお財布への負担も少なく養毛をご体感していただくことができます。髪の毛が薄くなると、あまり深く調べないうちに、すぐに見た目を戻そうと増毛や植毛も人気ですが、髪の毛や頭皮にかかる負担がかかることで前よりも頭皮や髪の毛が悪い状態になってしまうこともございます。
ヒト幹細胞培養液は肌のシワやほうれい線にも高い効果がございます。頭皮も明らかに健康に近づき、髪質の力強さで見違える変化を感じていただけることでしょう。
■実年齢より上に見られるようになったら『Step’sプログラム』

ヘアスタイルの役割はコミュニケーションにもとても重要です。見た目のアピールにも役立つ髪の毛は、少なくなってしまうと自信消失ややる気軽減などマイナスな気分になってしまいます。見た目にも影響がありますので、実年齢よりも上に見られてしまい、驚かれてしまったり、同年代と髪の量を比べてしまったりとネガティブになってしまいます。そんなネガティブな生活を続けている中でも髪の毛のボリューム低下の進行は止まることなく、さらにさらに髪の毛が気になってきてしまいます。生え際が明らかに後退するなど、はっきりと頭皮が露出してしまうと相手との何気ない会話でも、どうしても目線や見られ方が気になってきてしまいます。自信がない姿から覇気がないと感じ取られてしまい見た目の年齢も若々しさは伝わりづらくなります。
若々しいエネルギッシュな印象を持ってもらうためにも頭皮や毛髪に意識を向けて改善のための『Step’sプログラム』のご利用がおすすめとなります。
■カツラ派の方も並行して『Step’sプログラム』

カツラのメンテナンスの面倒さや、カツラであることがバレるのでないかという不安。さらにはピンで髪に取り付けるタイプのカツラの場合、ピン止めをしている部分の毛が引っ張られてしまい部分的な禿げになることも。カツラでは髪型が全く変わらない為、職場などでは周りからも違和感からバレてしまう可能性も高く注意が必要です。お仕事中にカツラを着用している方でも、『Step’sプログラム』では完全個室の中で着脱と帰宅時のヘアセットも可能です。
頭皮マッサージはドライ状態で行いますので、お仕事帰りや少しの空き時間での立ち寄りなどにも最適です。脱カツラに向けて自然な毛量と髪の力強さに向けてプログラムを開始いたしましょう。
■増毛中の方も毛が絡まらないで施術可能!

増毛した髪は地毛が自然と伸びてくると毛根から浮いた状態になり、髪の絡まりが起きやすくなります。この際に無理に引っ張ってしまったり強引はブラッシングをしてしまうとさらに毛髪が絡まりやすく痛みやすくなってしまいます。『Step’sプログラム』では頭皮に幹細胞培養液を噴射塗布いたしますので頭皮に直にノズルを伸ばしていきます。赤色低出力レーザーはキャップタイプの被るレーザーとなりますので過度なブラッシング不要にて髪の毛の絡まりを気にせずにプログラムを進めていくことができます。
■『Step’s』メンズNAX五反田店

最寄り駅:山手線 五反田駅 徒歩1分
営業時間:11:00~19:30
定休日:無休
店舗電話番号:03-4405-4585
「Step’sプログラム紹介ホームページ」 https://www.scalp-salon.com
メンズNAX/男のセルフ脱毛 五反田店
脱毛サロン/セルフ脱毛サロンとしても併設しておりますので店内作りの参考にもどうぞご活用下さい。五反田店は地域密着型の脱毛とエステ、セルフ脱毛と頭皮、毛髪に特化したヘッドケア専門のスカルプメニュー『Step’sプログラム』をご用意しております。






















